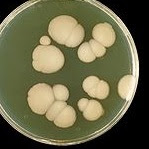

La candidiasis es una infección micótica (causada por hongos) por cualquiera de las especies de Candida (todas las levaduras), entre las cuales Candida albicans es la más común. También se le conoce como candidiasis, moniliasis y oportunista.
La cándida vive naturalmente dentro de nuestros intestinos en equilibrio con otras bacterias beneficiosas. En su existencia, la Candida produce 79 toxinas. Así que si el número de cándidas crece fuera de equilibrio y de la sana relación con otros microorganismos, los hongos de la levadura comienzan a degradar las paredes intestinales. Este deterioro de las paredes intestinales permite que los subproductos de las levaduras y otras moléculas de alimentos inadecuados entren en el torrente sanguíneo.
Una vez en el torrente sanguíneo, la cándida, sus subproductos y otras sustancias, tienen acceso a todo el cuerpo. Como resultado, las personas pueden tener síntomas que aparecen totalmente ajenos a la cándida.
Si lees inglés, te recomiendo visitar http://www.sheilashea.com/candida.html con información muy completa, práctica y fundamentada.
CAUSAS
Las causas son muchas y variadas. La sobre población de la cándida puede ocurrir cuando el balance entre bacterias y hongos en los intestinos se ve afectado negativamente por:
- dieta que incluye azúcares y harinas refinadas (el alimento de las levaduras), el consumo de alcohol, conservas, ahumados, alimentos fritos; medicamentos como antibióticos, vacunas, esteroides, píldoras anticonceptivas;
- sustancias químicas tales como la amalgama, el mercurio y otros metales tóxicos,
- pesticidas, aspartame, o desodorante vaginal, jabones o baño de burbujas perfumado
- llevar shorts de lycra o ropa apretada de nylon
- enfermedades como la diabetes mellitus, el estreñimiento crónico o diarrea,
- relaciones sexuales con alguien que tiene una infección de candidiasis
- y desequilibrios mentales y emocionales.
SÍNTOMAS
¿Cuáles son algunos síntomas comunes de la candidiasis? ¿Cómo puedo saber si tengo sorepoblación de cándida?
Mucha gente muestra signos de sobrecrecimiento de la población de levadura sin saber cuál la causa subyacente. La candidiasis es difícil de diagnosticar por medio de pruebas de laboratorio, ya que todos tenemos levadura Candida albicans y otras, presentes naturalmente en nuestros cuerpos, incluso cuando estamos perfectamente san*s.
Los síntomas de la candidiasis son:
Gastrointestinales: indigestión, gases, hinchazón, inflamación, dolor, diarrea, estreñimiento, acidez estomacal, mal aliento, seca boca, revestimiento en la lengua, aftas.
Somáticas y alérgicas: adormecimiento, quema o hormigueo y articulaciones dolorosas, inflamadas o rígidas (ver dieta para combatir la artritis); dolores y tensión musculares, congestión nasal, tensión de cabeza, dolores de cabeza, visión borrosa, tinnitis, falta de aliento, dolores en el pecho, mareos, sinusitis, sensibilidad química.
Mentales y emocionales: depresión, confusión mental, insomnio, nerviosismo, ansiedad, desorientación, problemas de decisión, baja energía, hiperactividad, agitación.
Piel: parches de de hongos blancos en la piel como caspa, acné, sudoración con mal olor o pie de atleta, picazón anal, erupciones, psoriasis, dermatitis, impétigo.
Sexuales: vaginitis, descarga, prurito, infección de vejiga, irregularidades menstruales, dolor, calambres, disminución libido, infertilidad, impotencia, problemas de próstata.
Urinarios: Frecuente micción, quema y ganas de orinar, retención de líquidos, edema.
Es necesario aclarar que este es un padecimiento que enfrentan hombres y mujeres, y que se manifiesta no sólo en los órganos reproductores, sino también en la lengua, la piel, las encías. En muchos casos, no tiene manifestación tópica.
TRATAMIENTOS
En la medicina alópata existen tratamientos que básicamente lo que hacen es disminuir (o eliminar) la población de hongos en nuestro cuerpo. Sin embargo, éstos también son necesarios -en una cantidad adecuada- para nuestra salud y equilibrio; además la cándida se va haciendo cada vez más resistente a los antibióticos.
Independientemente de que sí existan muchos tratamientos eficaces en la alopatía y farmacia, existen otros procedimientos útiles como los sugeridos por la homeopatía y la acumpuntura.
En esta publicación hablaremos de algunas alternativas por medio de la alimentación para contribuir a restablecer el equilibrio en el cuerpo.
La dieta que contempla lo que aquí se sugiere puede llevar tiempo para mostrar sus efecto. La recomendación es aplicarla al menos tres meses y ver los resultados; sin funciona, continuarla. Algunas sugerencias además, son buenas para tu salud para el resto de la vida. Es importante seguir un tratamiento e implementar las modificaciones en los hábitos alimenticios y comportamientos para superar la candidiasis.
ALIMENTOS
Algunos alimentos son mejores que otros para el tratamiento de cándida y otros simplemente colaboran en su sobrepoblación. Ayudar a restaurar un flora intestinal amigable, consumir alimentos sanos y nutritivos que, naturalmente, apoyan el sistema inmunológico del cuerpo, hacer un tratamiento eficaz contra la candidiasis en casa y retornar a la salud son los objetivos de esta publicación.
QUÉ EVITAR
Si tienes Candidiasis, lo primero es una dieta de limpieza. Así es, lo primero es eliminar aquellos elementos que son el alimento de las levaduras, pero que no necesita tu cuerpo.
Evita:
- todo lo que tenga azúcar, edulcorantes artificales o esté endulzado (excepto estevia),
- harinas procesadas o refinadas (pan, pasta, etc.)
- los productos lácteos (excepto el yogur con lactobacilos),
- café, té negro, bebidas con cafeína, colas, alcohol,
- encurtidos y vinagres (excepto el de manzana),
- hidratos de carbono, preservantes, alimentos procesados, carnes ahumadas y embutidos.
Cuando hay candidiasis, el hígado suele estar bastante comprometido, así que te recomiendo también la dieta para desintoxicar el hígado.
ALIMENTOS CON PROPIEDADES FUNGICIDAS
La mayoría del crecimiento excesivo de la candida ocurre en el tracto digestivo, así que las hierbas fungicidas, como alimentos o infusiones, realmente son eficaces. Incorporar estos alimentos de forma sustancia en su dieta puede causar reacciones fuertes, así que consulta a una especialista para obtener más información sobre cómo empezar.
Vinagre de sidra de manzana
Además de usarlo liberalmente en aderezos de ensaladas, adobos y mayonesa, el vinagre de sidra de manzana puede usarse como una ducha en el tratamiento de las infecciones de levadura candida vaginal, o como un tratamiento tópico de micosis de la piel, incluyendo caspa, dermatitis de tiña versicolor y seborreica, que se producen por un sistema inmunológico debilitado.
Aceite de coco
Contiene ácido caprylico, un ácido graso que se ha demostrado que inhibe el crecimiento de los hongo, tanto tópicamente como internamente. Se puede comer crudo con verduras cocidas al vapor, o agregándolo a un plato de sopa. Este es uno de los más poderosos alimentos para el tratamiento de la cándida. Además, los aceites de coco son mejores que la mayoría de los aceites para cocinar debido a su tolerancia al calor.
Una recomendación: Bajo ninguna circunstancia compres aceites hidrogenados.
Ajo
Es el alimento antimicótico más poderoso para los tratamientos contra la cándida albicans. El ajo fresco contiene una gran cantidad de azufre que contiene compuestos con potentes propiedades fungicidas. Cuando se come crudo (especialmente aplastado, que expone estos poderosos agentes), es el mejor fungicida disponible! Lo puedes mezclar en los aderezos para la ensalada y picado crudo en salsas frescas y salsas de verdura cruda. Es también un poderoso agente para matar parásitos en el cuerpo y ayuda en la regulación de la presión arterial. Es mejor tomarlo crudo, y no te recomiendo que lo tomes en tabletas, pues es posible que éstas ya tengan mucho tiempo y que hayan perdido bastante de sus propiedades curativas.
Orégano
Contiene un fenol que es el agente antimicótico de la planta. Tiene un sabor muy fuerte, pero me encanta absolutamente! Se puede agregar al aderezo de ensalada, o añadir unas gotas a una porción de salsa de carne de buen estilo italiano. El orégano es uno de los mejores tratamientos orales contra la Cándida albicans en la boca. Se puede mezclar con aceite de oliva para aplicar a las infecciones de hongos de piel, o utilizar directamente.
Agracejo (Berberis vulgaris)
Contiene berberina, que tiene propiedades antimicóticas potentes. La berberina tiene una actividad fungicida significativa, dejando intacta la microflora beneficiosa en el intestino. Es también es buena contra la diarrea. Las investigaciones han demostrado que la berberina puede impedir efectivamente que levaduras produzcan lipasa, una enzima que utilizan para ayudarles a colonizar. Además, esta planta se ha utilizado desde épocas muy antiguas para los trastornos digestivos, infección, indigestión, enfermedad de la vesícula biliar y reflujo gastroesofágico.
Hydrastis canadensis
Llamada Goldenseal en inglés, es un poderoso antihongos, por lo que es genial como parte de un tratamiento para cándida. Su raín contiene berberina.
Pau d' arco
Se trata de un fungicida, más suave que está hecho de la corteza de un árbol del bosque lluvioso. A veces se denomina Taheebo o Lapacho. Puedes obtenerlo en bolsitas de té.
Además, podemos incluir en la diea la canela, el tomillo, el cilantro, el clavo de olor, la regaliz (evita los antojos de azúcar), la manzanilla (estimula la producción de ácidos estomacales para mantener el equilibrio alcalino/ácido en el sistema digestivo), el hinojo y el cardamomo.
Una dieta natural que mantiene el sistema digestivo completamente funcional y aumenta la inmunidad es una solución a largo plazo para evitar la candidiasis. Si ya tienes sobrepoblación de cándida, es importante facilitar la limpieza del tracto digestivo aumentando tu ingesta de agua y evitando a toda costa el estreñimiento.
TESTIMONIO:
Durante casi dos y medio años estaba muy enferma. Mi respuesta inmune se redujo y estaba plagada de cada infección que había y tenía dificultades para recuperarme. He tenido infecciones de vejiga constantes, infecciones de nariz y garganta, fatiga crónica, estreñimiento constante, hinchazón, aumento de peso, depresión, problemas hormonales, pérdida de pigmentación del cabello, piel seca y alergias. Después de meses de investigación, descubrí que todo podía deberse a una candidiasis.
Comencé a tratarme con plantas y dejé totalmente el azúcar y los carbohidratos. Cinco meses después la diferencia era más que evidente!
He decidido eliminar completamente el azúcar de mi dieta y continúo tomando las hierbas, que además tienen rico sabor. Ya no me he enfermado, me siento más joven y estoy libre de todos los síntomas.
VITAMINAS Y MINERALES
Biotina
Es una vitamina B, es esencial para el metabolismo de las grasas y proteínas. Se cree que juega algún papel importante en la prevención del exceso de cándida. Yamaguchi y sus colegas encontraron que tomar 300 mgs de biotina y dos cucharadas de aceite de oliva verde tres veces al día previene la conversión de la levadura que comemos en hongo. Al menos seis meses son necesarios para obtener un buen resultado.
Los antioxidantes
Fortalecen el sistema inmunológico.
Las vitaminas A y C
Ayudan en el tratamiento de la infección resultante de hongos micropunctures en las paredes intestinales.
El cobre y el zinc
Las personas con cándida, parásitos o el virus Epstein - Barr tienen comúnmente un exceso de cobre y mercurio en su cuerpo.
Germanio
El científico japonés Asai encontró que una dosis de 100-300 mgs por día de germanio mejora frente muchas enfermedades incluyendo la candidiasis. La investigación muestra germanio orgánico aumenta la oxigenación de tejidos.
Calcio iónico
Una teoría señala que una deficiencia de calcio iónico (y otros minerales alcalinizantes) se encuentran en la raíz de cándida y de la diabetes juvenil. La acidosis se desarrolla sin estos minerales.
CONCLUSIONES
Invertir la presencia de la candida toma tiempo. Cuando el cuerpo desarrolla una enfermedad como la candidiasis, tenemos que hacer esfuerzos heroicos para crear el equilibrio original de la flora intestinal.
El esfuerzo vale la pena. Algunas personas sienten que se recuperan a sí mismas, cuando eliminan los efectos emocionales secundarios de la candidiasis como la depresión, el insomnio, el agotamiento, la pérdida de memoria, la irritabilidad, las quejas, la ira, la ansiedad y el estado de ánimo que suba y baja, derivados de toxinas que las levaduras pueden llegar a liberar en exceso en el cuerpo. Y eso sin contar la picazón que algunas personas experimentan!
Si te fijas, eliminar los alimentos que contribuyen a la sobrepoblación de la cándida e incorporar los que la mantienen controlada sanamente (sin matar todo lo demás), es algo que sin duda, aunque no tengas candidiasis, mejorará tu vida.
*
- Directorio de recomendaciones para el tratamiento de enfermedades
- Directorio de plantas medicinales
- Directorio de publicaciones para una buena nutrición
Y si deseas atención personalizada, visita: consultas y terapias individuales.
*

17 comentarios:
Hola llevo mas de un año con candidas,tomando antifungicos y poniendome ovulos y nada siempre volvia ,ahora hago la dieta ,tomo ajo y aloe vera cada dia y debo decir q usar la planta de aloe vera me ha venido muy bien...corto un trocito de la parte cristalina de la hoja y la uso como ovulo,es lo unico q hace desaparecer los sintomas vaginales para mi por lo menos estoy contenta y me siento muy aliviada ya te contare como sigo ...ahhh mira hago muxas de las cosas q recomiendas...gracias por la informacion
Es fabuloso saber que hay plantas tan buenas que pueden curar todo, hasta las candidiasis, yo no sabía como se manifestaban hasta que lei en www.candida.es realmente es importante cuidar el organismo, y comer saludable
Yo he conseguid curarme de la candidiasis después de muchos años de enfermedad, y los consejos que das me parecen muy acertados.
Para mi el primer paso fundamental fue modificar mi alimentación. Este paso me llevo mucho tiempo, porque al ponerte tantas restricciones de alimentos al principio resulta muy dificil seguirla. Pero después de muchos años de pruebas di con recetas deliciosas con las que no me sentía a dieta en absoluto. Hoy quiero compartirlas con todos los que esteis sufriendo esta enfermedad, porque se que os pueden motivar a llevar la dieta anti cándida que os ayude a recuperar vuestra salud.
Podeis verlas en la web que hemos desarrollado www.dietacandida.com , donde también podrás descubrir más de 110 deliciosas recetas para la candidiasis y leer mi historia completa, que seguro que te resulta familiar y motiva a realizar cambios en tu vida.
Carlota
Hola, ésta enfermedad es realmente fea... llevo más de tres años con ella y conozco muchos medicamentos químicos, que no funcionan, me he pasado por la web una infinidad de veces y por en encuentro un sitio con tanta y acertada información. Muchas gracias, la dieta ya la he iniciado hace una semana, sin embargo, no sé como erradicar los síntomas vaginales que son verdaderamente molestos y desagradables, por no decir lo menos. Una compañera que conoce de plantas me recomendó que me hiciera una ducha con la decocción de las hojas de guacimo, al principio fue bueno y sentí bienestar, pero luego de una semana los síntomas aparecieron de nuevo. Los médicos insisten en mandar las mismas cremas, los mismos óvulos, las mismas pastillas que desafortunadamente no sirven para sangre, pero si para deteriorar aún mas hígado y el sistema inmunológico de mi cuerpo.... ahhhh que hacer? Cambiar la dieta e insistir en las duchas vaginales con extractos de plantas... muchas gracias por tu información, (apenas me entero que los demás síntomas que he tenido hace un largo tiempo ya, son razón de la cándida...)
Seguiré visitandote... nos vemos!
Hola Paula!
Para disminuir las molestias te recomiendo duchas vaginales con vinagres de manzana.
Resultados mas permanentes los verás después de meses de hacer la dieta, evitando los alimentos que estimulan el crecimiento del hongo en nuestro organismo. Animo, percevera!
A
Gracias por tu comentario, abrazo!
Saludos!!!
Mil gracias por esta información, me ha sido de mucha ayuda ya que durante mucho tiempo he batallado con esta enfermedad y en realidad estoy desesperada ya que el tener constantemente flujo vaginal es bastante incomodo, afortunadamente no tengo ningún otro síntoma mas que este (el flujo abundante, blanco y espeso) pero en realidad es bastante incomodo... Aun recuerdo que me causaba admiración e incredulidad cada que iba a realizarme mi papanicolao y la chica que me lo hacia siempre me decía: "debes modifical tu alimentación, no comes nada de frutas ni verduras" a lo que yo le respondia y tu como sabes eso? ella decía -"porque tienes mucho flujo, te faltan frutas y verduras"... el resultado de mis papanicolaos siempre arroja inflación grado 2 y candida albicans... Con toda esta información que tan amablemente proporcionas, entiendo la importancia de una sana alimentación!!!
Ahora solo espero pronto poder acabar con estos molestos síntomas...
Muchisimas gracias, saludos cordiales y un gran abrazo!
Buenos dias! He estado buscando informacion respecto a candidiasis ya que mi nena de 4 años tiene tiempo con dolores estomacales y un sinnúmero de síntomas que vienen y se van y sospecho que es candidiasis.Todo empezó después de tomar varios ciclos de antibióticos recetados por su doctora por una infección en el oído, mi nena empezó con dolores de estómago y una especie de gripa que se le quedaba por una semana y regresaba a la siguiente, en fin que le compre un kit de vitaminas por que no quiere comer y note que con las vitaminas el dolor de estómago era más deje de dárselas le hicieron ultra sonidos salieron normales, hoy amaneció con dos llagas en su labio y el dolor estomacal fuerte ya no confío en la medicina moderna y me gustaría intentar un tratamiento natural por favor alguien que pueda ayudarme no se como empezar una dieta para mi nena que sea natural y segura! Gracias.
Mama desesperada!
Buenos dias! He estado buscando informacion respecto a candidiasis ya que mi nena de 4 años tiene tiempo con dolores estomacales y un sinnúmero de síntomas que vienen y se van y sospecho que es candidiasis.Todo empezó después de tomar varios ciclos de antibióticos recetados por su doctora por una infección en el oído, mi nena empezó con dolores de estómago y una especie de gripa que se le quedaba por una semana y regresaba a la siguiente, en fin que le compre un kit de vitaminas por que no quiere comer y note que con las vitaminas el dolor de estómago era más deje de dárselas le hicieron ultra sonidos salieron normales, hoy amaneció con dos llagas en su labio y el dolor estomacal fuerte ya no confío en la medicina moderna y me gustaría intentar un tratamiento natural por favor alguien que pueda ayudarme no se como empezar una dieta para mi nena que sea natural y segura! Gracias.
Mama desesperada!
yo llevo 29 años con candida, por si alguien se queja de llevar semana o meses. Lo cierto es que yo no sabía de donde rayos me provino ese mal, que hasta ahora me da los sintomas de fatiga crónica porque siempre me siento muy cansada, mi cabello se cae, mi piel se mantiene reseca al grado de tener que usar mucha crema y agua para mantenerla hidratada, actualmente siento resequedad en mi parte intima pero no sabía porque era todo esto, nunca lo relaciones con este mal y tampoco creí que aquejara a tantas mujeres, crei que era una de las pocas por padecerlo, pero lo que sí creo es que soy una de las pocas que lo ha padecido por tantos año, al grado de darme por vencida por que nada me ha resultado. Realmente ha sido una pesadilla todos estos año, mi falta de economía tambien no me ha ayudado mucho para contrarrestar este síntoma, pero aunado a esto mi pregunta además es si esto en un momento dado que me quiera embarazar podría tornar algún riesgo a la hora de fecundar?? o de lograrse un embarazo, podría afectar de alguna manera al producto??
Les cuento, yo eh padecido este hongo hace un año y todo mi sistema inmunológico se veia afectado, me habia salido un quiste en la tiroides así que tambien comenze a sufrir hipotiroidismo, pero me daban infecciones de todo tipo,vivia enferma de gripe y de garganta, de las vias urinarias.. a veces hasta no podia hacer pipi.. luego de un año comenze una dieta porque mi higado se puso graso,reemplaze el pan refinado por el integral, todo lo que comenze a consumir fue integral, frutas, verduras, te de limón , y todos los días me comia un yogur con cereales y miel, tambien consumo almendras todos los dias y mas la levotiroxina el quiste de mi cuello se fue por completo, el higado comenzo a curarse pero formo unos calculos pequeños de los que todavia debo hacerme cargo n_nU y lo mejor de todo es que me purifique.. baje 6 kilos,aunque mi peso estaba bien puedo ver mis huesos, asusta un poco al principio sobre todo mis seres queridos se espantaron al verme flaca, se impresionaron pero no quede como una anorexica sino normal.. y lo mejor de lo mejor es que en todo el invierno con nieves lluvias torrenciales que me empapan completamente y con toda la gente que tengo que hablarle no me pesco resfriados ni gripes.. y todo esto es gracias a la dieta.. así que a todos les digo, cuiden sus dietas, la alimentación es la llave de la cura, hasta el cancer se puede curar con dieta y sobre todo con las ganas de vivir, la fé la esperanza y el esfuerzo, la fuerza de voluntad.. ustedes pueden curarse.. todos pueden curarse, solo hay que estar bien siempre, no se entristezcan siempre rezen a Dios, pidan sabiduria, agradezcan todo lo que tienen, tengan mucha voluntad y esfuerzence mucho y todo saldra bien. bendiciones a todos, mucha paz y armonía, les deseo el bienestar amen.
Me recetaron bicarbonato ingerido con agua tres veces al dia, tomar tres capsulas de ajo al dia y baños de asiento con bicarbonato para las molestias genitales. En un mes estoy curada y mis niveles de este hongo se han normalizado, despues de seis años sufriendolo. Ojalá estos consejos os sirven como a mi me sirvieron!
_hola yo llevo casi dos años con la candida, me trate con muchos medicamentos pero nada servía, después comwnze hacer una dieta así como la que mencionas que la verdad me a dado mucho resultado y EH tomado un antifúngico que se llama candida forte de laboratorios nature plus, son naturales y también me han servido bastante, gracias a mi esfuerzo y dedicación para curarme ybradicar este hongo, hice muchos esfuerzos, pero la picazón interna de mi vagina fue disminuyendo, no me duele el vientre, solo que el flujo vaginal sigue, y es aaaaaaaa demasiado molesto hice las duchas vaginales con vinagre de manzana pero no me funciono al principio si después otra ves y así así que decidí ya no hacerlas después con aceite de árbol de te y también lo mismo ahora comenze a hacer duchas con agua natural y poniéndome óvulos que fortalecen la flora vaginal y colocarme yogurt natural en la vagina dentro y fuera a ver que tal , muchas gracias por la información, y animo a todas todo en esta vida se puede muchos ánimos y alegría que la candida también se alimente de la depresión y estres. Saludos!
Hola yo encontré un canal en youtube. Se llama metabolismotv. Con Frank suarez. Mi cuñada estáva muy enferma. Desde asía mucho tiempo Ivan a quitarle la matriz por todos los problemas hormonales q tenía por causa de la candidiasis pero se empezó a tratar y hoy por hoy es una mujer saludable. Si ay tratamientos eficaces. D verdad se los recomiendo. Bendiciones
Hola, yo padezco esta terrible enfermedad por mas de 6 años, y hasta ahora me vengo dando cuenta los terribles síntomas que he venido sintiendo, mis citologias siempre arrojaban inflamacion y mi Gine lo que me decía tienes muchos honguitos, pero como no le hablan claro a uno que va a saber uno, ahora entiendo todo esto. Hace poco cambie mi alimentacion por completo elimine la harina y el azúcar,me he sentido mucho mejor a nivel estomacal; sin embargo continuo con el mal de mi vagina, voy a seguir sus consejos con buscar plantas medicinales para lograr una vida sana y poder disfrutar de los regalos de la vida. Gracias por las recomendaciones, es bueno saber que en el mundo existen personas que comparten sus aprendizajes con los demás. saluditos desde venezuela.
Yo tengo como ocho meses con este problema, me identifico mucho con tus síntomas, principamente con la sequedad vaginal y en la piel. Me acaba de revisar un equipo de médicos y me expresaron que tengo mucha deshidratación y mi vagina tiene la textura e hidratación de una anciana, tengo 27 años.
Tengo que tomar tres litros de agua al día, aloe vera o sábila y aplicarme en la vulva también aloe vera o sábila, íntentalo si gustas.
Por los cambios climaticos y fisicos de la tierra enfrentamos los desafíos de la nueva agricultura, los Fungicidas diocrop
Somos una empresa dedicada a la búsqueda de soluciones creativas e innovadoras.
Hola, yo lo sufro hace más de 15 años (desde los 19años) con tratamientos por ginecología y dermatología que me decian eran normales, que a todos les pasaba. Pero tenía los sintomas desde los 5 años y cuando mi mamá me llevaba al médico se reian de ella y opto por no llevarme mas. Ahora con mis 35años y después de 2 años de abandonar mi vida por buscar un tratamiento que me sirva descubro que no, que no era normal y fue la causa de la debilidad en mi sistema inmunologico provocandome o haciendo mas graves las incontables enfermedades, cirugias y problemas que tuve en tantos años. Aun hoy voy al méfico y veo es todo como muy nuevo, algunos saben lo que es, otros lo ignoran o no lo creen y envian al psiquiatra, otros se interesan e investigan. Espero despues de tanto estar yendo por el camino correcto y que al fin logre la mejoria. La manzanilla, el aloe vera, dieta entre otras cosas me estan ayudando mucho, pero esto recién empieza.. gracias x el espacio
Publicar un comentario